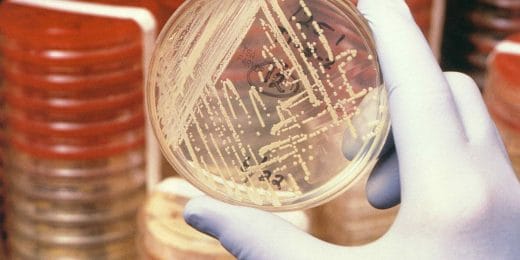

Vaccin tegen malaria op komst
Nog altijd sterven jaarlijks honderdduizenden mensen in...
Lees Meer +
Buiktyfus herkennen en voorkomen
Tyfus, het is volgens velen een ziekte uit vervlogen ti...
Lees Meer +
Chikungunya
De tropische ziekte chikungunya is een virusinfectiezie...
Lees Meer +
Is MERS het nieuwe SARS?
De wereld is in de ban van het MERS-virus, dat in Zuid-...
Lees Meer +
MRSA
Iedereen die wel eens in een ziekenhuis is geweest, hee...
Lees Meer +
Besmetting door legionella: de veteranenziekte
In de volksmond wordt een zware longontsteking als gevo...
Lees Meer +
Hoe is het nu eigenlijk gesteld met SARS?
In 2002 en 2003 werd de wereld opgeschrikt door de snel...
Lees Meer +
Griepepidemie: hoeveel mensen hebben er dan ook echt griep?
Jaarlijks heerst er wel weer een griepgolf. Gedurende e...
Lees Meer +
Q-koorts
Wereldwijd komt de infectieziekte Q-koorts voor. Vanaf ...
Lees Meer +
Vogelgriep gevaarlijk voor mensen?
Aviaire influenza, in de volksmond bekend staande als v...
Lees Meer +